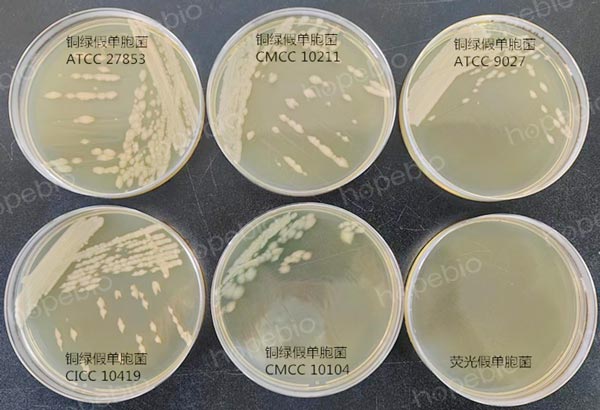
42℃条件下培养，铜绿假单胞菌和荧光假单胞菌的生长状态

海博微信公众号
海博微信公众号
 海博天猫旗舰店
海博天猫旗舰店


 海博微信公众号
海博微信公众号
 海博天猫旗舰店
海博天猫旗舰店




一、标准简介
在饮用天然矿泉水检验方法(GB 8538)中,铜绿假单胞菌的检验一直是一个必检项目。新版《GB 8538-2022 食品安全国家标准 饮用天然矿泉水检验方法》已于2022.6.30发布,2022.12.30正式实施。与旧版本相比,新版标准中,增加了对铜绿假单胞菌进一步确证相关的内容(如图1),并对菌数计算方法做了相应调整。本文主要阐述这些增加的内容。

图1 饮用天然矿泉水中铜绿假单胞菌的检验程序
二、绿脓菌素生长试验
旧版标准《GB 8538-2016 食品安全国家标准 饮用天然矿泉水检验方法》中,在CN琼脂培养基上培养出的蓝色或绿色菌落直接判为铜绿假单胞菌;但在新标准中,对于这种蓝色或绿色菌落,需要通过绿脓菌素试验进行确认,结果阳性(产绿脓菌素)者,方可判为铜绿假单胞菌。
有关绿脓菌素试验,具体操作如下:
将在CN琼脂上呈蓝色或绿色菌落的纯培养物分别接种在绿脓菌素测定培养基上,36℃±1℃培养24h±2h,加入三氯甲烷3mL~5mL,可捣碎培养基并充分振荡使培养物中的绿脓菌素溶解于三氯甲烷,待三氯甲烷提取液呈蓝色时,用吸管将三氯甲烷移到另一试管中,并加入1mol/L的盐酸1mL,振荡后,静置片刻。如上层盐酸液内出现粉红色到紫红色时为阳性,表示被检物中有绿脓菌素存在。
具体操作结果判别,可参考文章:绿脓菌素测定(PDP)实验文章 点击查看 视频:绿脓菌素(PDP)测定实验 点击查看视频
三、42℃生长试验
旧版标准《GB 8538-2016 食品安全国家标准 饮用天然矿泉水检验方法》中,在CN琼脂培养基上培养出的发荧光、非蓝色且非绿色的菌落,只需进行产氨试验确证,结果为阳性的即可判为铜绿假单胞菌;但在新版标准中,除了要做产氨试验外,还要进行42℃生长试验,结果也为阳性的,才能确认为铜绿假单胞菌。
这个试验的引入,可以有效避免其它假单胞菌(如荧光假单胞菌)对检验结果的干扰。荧光假单胞菌也能产生荧光,但其生长的温度范围为4℃-37℃,在42℃条件下培养,完全不能生长(如图2)。通过这个试验,可以有效减少铜绿假单胞菌的假阳性结果,更加客观地反应出样品的真实情况。
图2 42℃条件下培养,铜绿假单胞菌和荧光假单胞菌的生长状态
综合比较,新版本标准对于CN琼脂上培养出的蓝色或绿色菌落及发荧光、非蓝色且非绿色的菌落,需要分别增加绿脓菌素试验和42℃生长试验进一步确证;而对于不发荧光的红褐色或其它颜色的菌落,则保持旧版标准的判定方法(如表1)。
表1 铜绿假单胞菌的确证试验

四、计数方法
(1)由于上述确认方法的引入,旧版标准中的菌数计算方法明显存在不足(如图3);

图3 旧版标准中铜绿假单胞菌菌数的计算方法
从而在新版标准中,也一并做了相应的修改(如图4)

图4 新版标准中铜绿假单胞菌菌数的计算方法
五、讨论
除了上述确证方法有所改变之外,对于可疑菌落数的挑选和阴性对照菌等方面,都有调整,相关检测人员在实际工作中,要加以区分,尽量按照新标准的要求进行相关检验操作。
相关标准:
GB 8538-2022 食品安全国家标准 饮用天然矿泉水检验方法 -点击标准下载
注:本文属海博生物原创,未经允许不得转载。
下一篇:样品中大肠埃希氏菌的分离方法解读
| 相关文章: | ||



